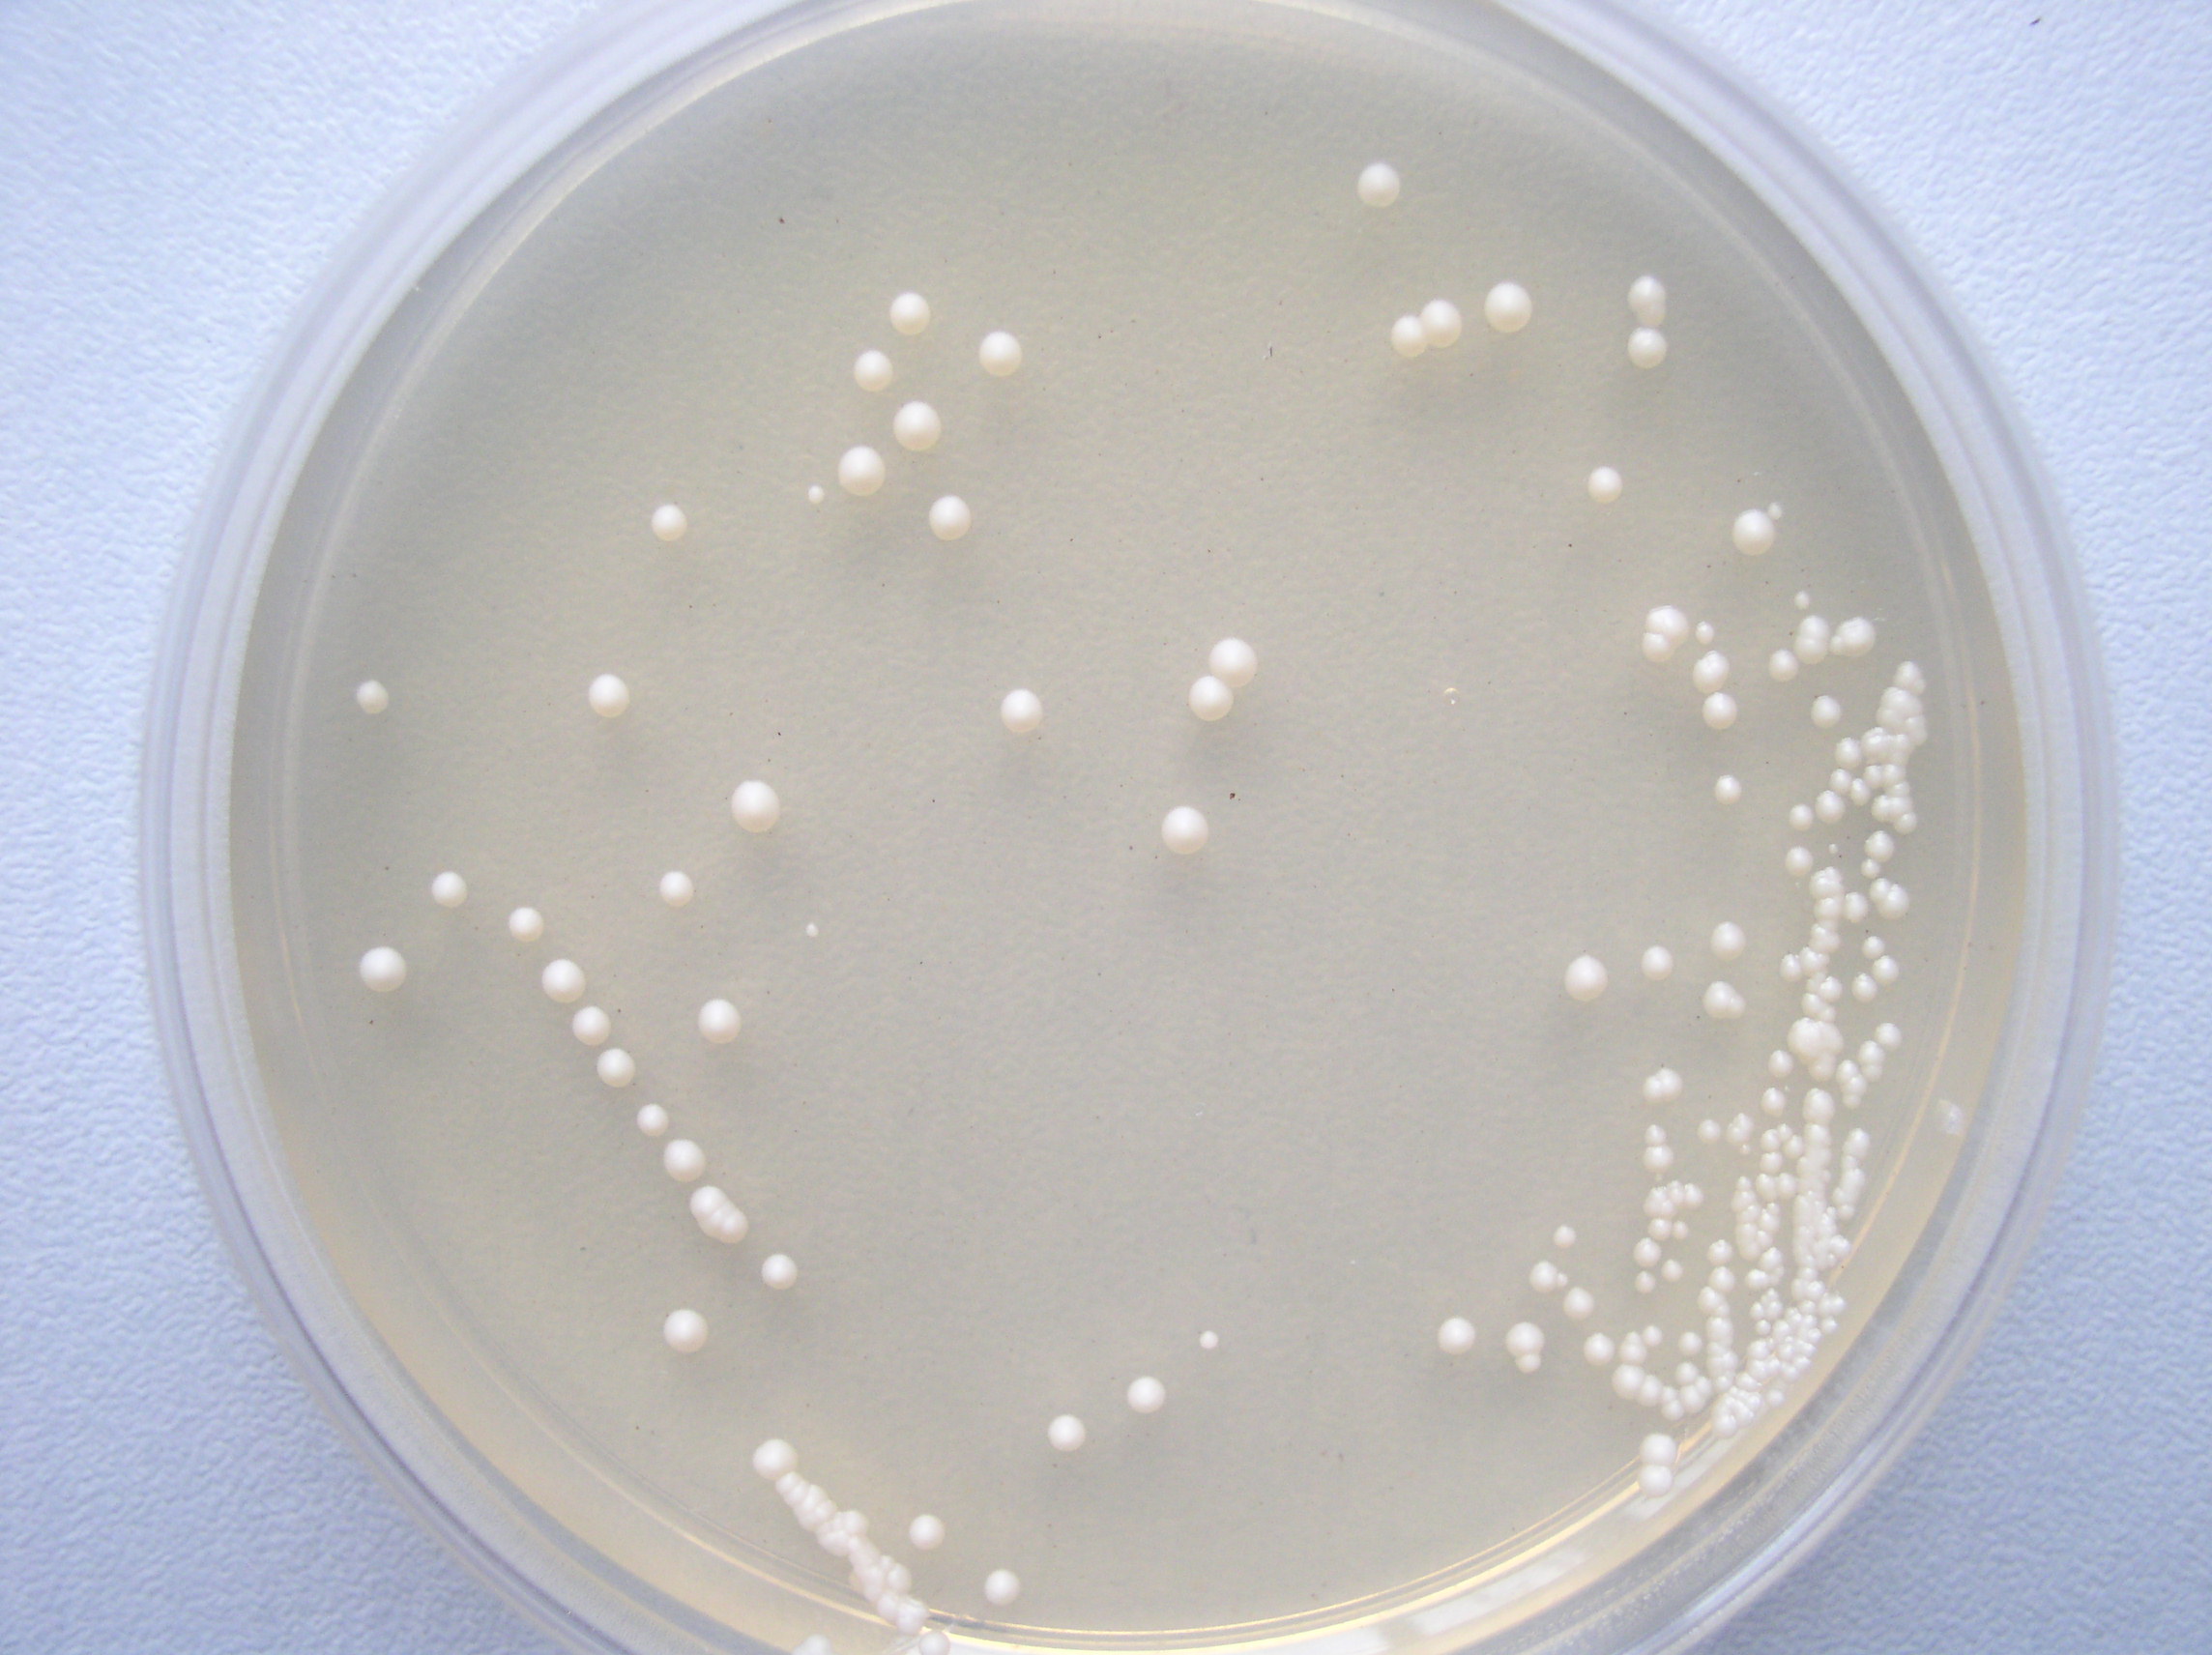
酿酒酵母

酵母菌菌落

活性酵母菌的作用与功效护肤品挑选有特异性酵母菌的差别有多大
图片尺寸500x398
同种酵母菌但是菌落形态不一样这是为什么呢
图片尺寸900x675
全部相册 > 酵母菌菌落及镜下特点( 16张 )
图片尺寸1280x960
酵母菌的菌落
图片尺寸900x430
检易霉菌酵母菌即用型平板 48小时计数 菌落无蔓延扩散#食 - 抖音
图片尺寸1080x1095
谁有酵母菌的菌落图片?麻烦传给我看一看!不胜感激!
图片尺寸640x480
酵母菌落图
图片尺寸854x640
求助交流请问大家这是酵母菌菌落的样子吗
图片尺寸800x600
谁有酵母菌的菌落图片?麻烦传给我看一看!不胜感激!
图片尺寸1632x1224
丁香园论坛
图片尺寸5184x3456酿酒酵母
图片尺寸2288x1712
作双杂交酵母平板长出红色小菌落
图片尺寸614x461
酵母平板菌落照片
图片尺寸500x375
谁有酵母菌的菌落图片?麻烦传给我看一看!不胜感激!
图片尺寸2048x1536
酵母浸出粉胨葡萄糖琼脂培养基菌落特征
图片尺寸2400x1200
酵母转化后除了有大的菌落还有一堆小菌落求助
图片尺寸507x900
而其他白色的污点则可能是葡萄球菌,橘色和黄色部分可能是酵母.
图片尺寸600x544
酵母菌平板上的菌落图片
图片尺寸2048x1536
求大神帮看看我筛出的菌落是不是酵母菌
图片尺寸675x900
新疆供应酿酒酵母菌,酿酒酵母
图片尺寸640x320
猜你喜欢:酵母菌平板图片酵母菌和霉菌的区别图白色念珠菌菌落酵母菌结构乳酸菌菌落特征铜绿假单胞菌菌落常见菌落图片酵母菌菌落特征酵母菌菌落形态酵母菌菌落图片孟加拉红酵母菌图片乳酸菌菌落形态图片常见细菌菌落图片酵母菌菌落形态特征霉菌酵母菌菌落图片霉菌酵母菌平板图片霉菌菌落特征酵母菌是真菌还是细菌菌落特征微生物细菌菌落图片假丝酵母菌大肠杆菌菌落放线菌菌落真菌菌落霉菌菌落图片真菌菌落图片常见菌落及颜色芽孢杆菌菌落酵母菌图片酵母菌显微镜下图片翻料机构彼岸壁纸4k动漫清朝北洋新军军刀价值华师宿舍伽罗脱小心超人的衣服祝妻子生日快乐图片博物馆古油灯图片裁判长丹尼尔图片豌豆肉末汤我的小小心愿绘画作品睡觉姿势绘画生日蛋糕卡片制作图片